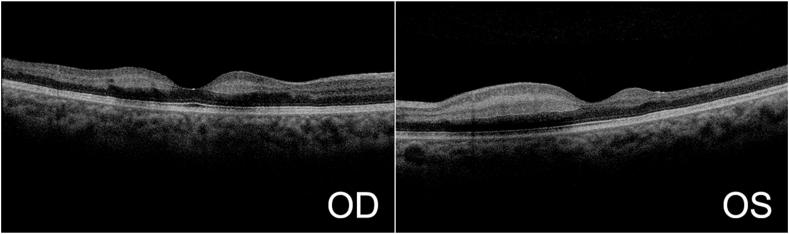
https://cdn.ncbi.nlm.nih.gov/pmc/blobs/2393/10468796/d997649185e5/gr3.jpg

患有血红蛋白SS病的儿科患者的急性黄斑梗死
Acute macular infarctions in pediatric patients with hemoglobin SS disease.
作者信息
Lee Patrick Sy, Alfaro Cesar, Me Rao, Lin Xihui
机构信息
Kresge Eye Institute/Department of Ophthalmology, Visual and Anatomical Sciences, Wayne State University School of Medicine, 4717 St. Antoine Street, Detroit, MI, 48201, USA.
出版信息
Am J Ophthalmol Case Rep. 2023 Aug 17;32:101913. doi: 10.1016/j.ajoc.2023.101913. eCollection 2023 Dec.
PURPOSE
To report two cases of symptomatic posterior pole arterial occlusions in patients with hemoglobin SS disease.
OBSERVATIONS
Two teenage patients with hemoglobin SS disease presented with visual distortions, and on dilated fundus examination and testing, they were found to have arterial occlusions involving the posterior pole. The patients were evaluated for stroke with head imaging and received exchange transfusion by hematology.
CONCLUSIONS AND IMPORTANCE
This case series reports the unusual findings of arterial occlusions in the posterior pole resulting in areas of retinal whitening and ischemia in patients with HbSS. While sickle cell retinopathy is typically considered a peripheral retinal disease, these findings underscore the importance of vigilance when examining patients with sickle cell disease.
目的
报告两例血红蛋白SS病患者出现症状性后极动脉阻塞的病例。
观察结果
两名患有血红蛋白SS病的青少年患者出现视觉扭曲,经散瞳眼底检查和测试,发现他们存在累及后极的动脉阻塞。通过头部成像对患者进行中风评估,并由血液科进行换血治疗。
结论与意义
本病例系列报告了血红蛋白SS病患者后极动脉阻塞导致视网膜变白和缺血区域的异常发现。虽然镰状细胞视网膜病变通常被认为是一种周边视网膜疾病,但这些发现强调了对镰状细胞病患者进行检查时保持警惕的重要性。